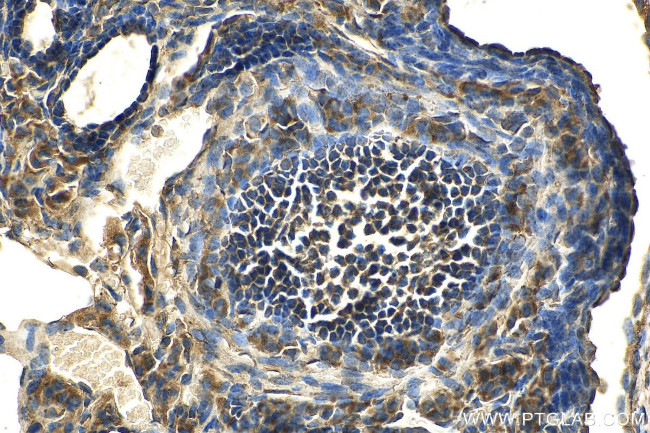
RAB14 Antibody in Immunohistochemistry (Paraffin) (IHC (P))

Search
Proteintech
RAB14 Monoclonal Antibody (3G7B3)
{{$productOrderCtrl.translations['antibody.pdp.commerceCard.promotion.promotions']}}
{{$productOrderCtrl.translations['antibody.pdp.commerceCard.promotion.viewpromo']}}
{{$productOrderCtrl.translations['antibody.pdp.commerceCard.promotion.promocode']}}: {{promo.promoCode}} {{promo.promoTitle}} {{promo.promoDescription}}. {{$productOrderCtrl.translations['antibody.pdp.commerceCard.promotion.learnmore']}}
产品信息
67953-1-IG150UL
种属反应
宿主/亚型
分类
类型
克隆号
偶联物
形式
浓度
规格
纯化类型
保存液
内含物
保存条件
运输条件
靶标信息
Localized to biosynthetic and endosomal compartments, Rab14 is involved in the biosynthetic/recycling pathway between the Golgi and endosomal compartments.
仅用于科研。不用于诊断过程。未经明确授权不得转售。
篇参考文献 (0)
生物信息学
蛋白别名: bA165P4.3 (member RAS oncogene family); F protein-binding protein 1; GTPase Rab14; Rab protein family member; RAB-14; RAB14; Ras-related protein Rab-14; small GTP binding protein RAB14; unnamed protein product; viral protein-binding protein; FBP1
基因别名: 0610030G24Rik; 2810475J17Rik; A830021G03Rik; AI314285; AI649155; D030017L14Rik; FBP; RAB-14; RAB14
UniProt ID: (Human) P61106, (Pig) Q52NJ6, (Mouse) Q91V41, (Rat) P61107
Entrez Gene ID: (Human) 51552, (Pig) 595112, (Mouse) 68365, (Rat) 94197